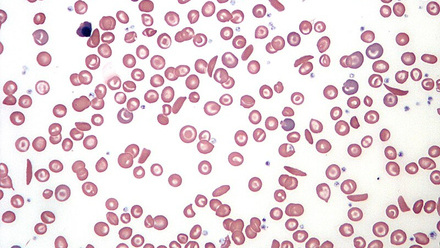
Sickle_Cell_Blood_Smear.JPG

NEWS & MEDIA
The Future Forum sparked conversation well beyond the walls of the ICC Birmingham. This page brings together media coverage, blog posts, press releases and updates related to the event and the wider movement it is helping to grow.
Here you’ll find stories that spotlight the people, research and ideas that shaped the 2025 programme, as well as coverage that reflects the growing momentum around equity, visibility and leadership in the life sciences.
As we continue to share insights and reflections from this year’s event, this section will grow to include delegate stories, organisational responses and key sector updates linked to the themes of the Future Forum.
10th April 2025
And the winners are! Our pitch perfect posters
More News
12th March 2025
Best foot forward - plan your journey to the Future Forum
28th January 2025
The Voice | Where are all the Black scientists?